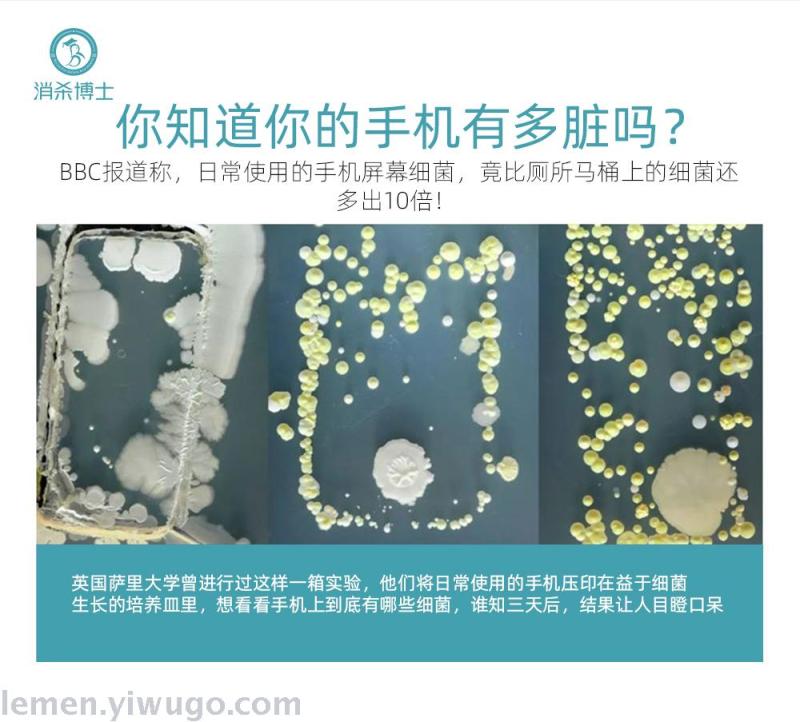

Search history
Clear allSearch by image
XDrag and drop an image here or upload an image
Max 5MB per image
UploadSign In | Join
X Email Mobile
YIWU SHUANGLI HARDWARE COMPANY 14yr.
Contacts:lemen Chat
Mobile:86-13362989178
E-mail:443694031@qq.com

Update time:
TOP